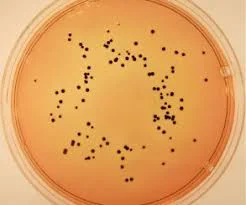
گلیسیرین صنعتی جامد

مواد شیمیایی
به آریاطب خوش آمدید، فروشگاهی برای تمام نیازهای مواد شیمیایی آزمایشگاهی شما. انتخاب گسترده ما از ترکیبات شیمیایی تضمین می کند که می توانید محصولات مناسب را برای هر آزمایشگاهی پیدا کنید. ما خرید مواد شیمیایی مناسب شما را در تهران و شهرستانها فراهم می کنیم. با قیمت های پیشرو در بازار و تیم باتجربه خدمات مشتری ما، می توانید به ما برای ارائه راه حل های سریع و مطمئن اعتماد کنید. چه حرفه ای باشید و چه تازه شروع به کار کرده اید، تضمین می کنیم هر آنچه را که نیاز دارید در اینجا در aryateb.com پیدا خواهید کرد. همین امروز خریداری کنید و از کیفیت باورنکردنی ما بهرمند شوید.
فروش مواد شیمیایی
مواد های شیمیایی از مهم ترین و اصلی ترین مواد هایی می باشد که در محیط آزمایشگاه از آن استفاده می کنند و همچنین برای تجزیه و آنالیز کردن مواد های دیگر با استفاده از تجهیزات آزمایشگاهی دیگر مورد استفاده قرار می گیرد .
خرید مواد شیمیایی
مواد آزمایشگاهی با توجه به کاربرد و نوع استفاده ای که دارند به دو گروه تقسیم می شوند : گروه مواد شیمیایی معدنی و مواد شیمیایی آلی بل گرید و درجه ی خلوص مختلف . مواد آزمایشگاهی به علت داشتن ترکیب های شیمیایی برای مصارف مختلفی مورد استفاده قرار می گیرد .

دانلود PDF لیست علائم اخطار مواد شیمیایی(GHS)
مواد آزمایشگاهی
کاربرد های مواد آزمایشگاهی عبارتند از " در صنایع پتروشیمی از مواد استفاده ی بسیاری می گردد ، در آزمایشگاه ها ، صنایع دارو سازی ، پزشکی ، علوم آزمایشگاهی از جمله : ژنتیک ، انگل شناسی ، کالبد شکافی ، صنایع غذایی ، گیاه شناسی ، صنایع رنگ و رزین ، در تولید و ساخت سرم و واکسن ، صنایع سرامیک و کاشی ، محیط زیست و منایع طبیعی ، آبکاری فلزات ، فاضلاب و تولید مواد شیمیایی _ بهداشتی .
استعلام قیمت مواد شیمیایی
گرید های مواد شیمیایی انواع فراوانی دارند که عبارتند از : گرید آزمایشگاهی با درجه ی خلوص 97 درصد ، گرید عمومی با درجه ی خلوص 95 درصد ، گرید تحلیلی با درجه ی خلوص 99 درصد .
.jpg)
انواع مواد شیمیایی
مواد های شیمیایی آزمایشگاهی مانند مواد دیگر در آزمایشگاه به حالت های جامد ، مایع ، گاز و پلاسما وجود دارند که هر یک با توجه به مدل کاربری و میزان درجه ی خلوص ، از گرید های آزمایشگاهی گوناگونی برخوردار می باشند .
تامین کننده مواد شیمیایی
مواد شیمیایی که گرید فنی دارند برای استفاده در صنعت پزشکی و دارو مناسب نیستند زیرا درجه خلوص کافی ندارند و شما می توانید از آن ها در شستشو و یا به عنوان حلال استفاده کنید . مواد شیمیایی با گرید خالص شده برای صنایع غذایی ، پزشکی و دارو سازی مناسب نمی باشد زیرا خلوص کافی ندارد و فقط می توانید از آن در برنامه های آموزشی استفاده کنید .
.jpg)
تولید مواد شیمیایی آزمایشگاهی
مواد شیمیایی که گرید آزمایشگاهی دارند برای مصرف آموزشی کاربرد دارد و به علت میزان خلوص گریدی که دارد برای مصرف دارویی و پزشکی قابل استفاده نمی باشد . در نتیجه مواد آزمایشگاهی از مهم ترین و اصلی ترین مواد مورد استفاده در محیط آزمایشگاه میباشند .
خرید مواد آزمایشگاهی شیمیایی
مواد آزمایشگاهی در انواع گوناگونی در فروشگاه آنلاین و دارای نماد اعتماد الکترونیکی آریا طب با قیمت مناسب به فروش می رسد می توانید از طریق همین سایت نسبت به خرید آنلاین این محصولات اقدام نمایید.
در نظر داشته باشید که مواد آزمایشگاهی در گرید مخصوص جایگاه خود با توجه به ویژگی یکسانی که دارند طبقه بندی می شوند البته در نظر داشته باشید که قبل مواد آزمایشگاهی مکانی که به عنوان آزمایشگاه انتخاب می کنید با تمام شرایط سازگار و همخوانی داشه باشد زیرا گرید هایی که به عنوان طبقه بندی مواد آزمایشگاه انتخاب می کنید امکان دارد بعضی سمی برخی احتیاج به هوای آزاد داشته باشد و آزمایشگاه باید دارای تهویه هوای مطبوع و دارای هود و مکانی باز باشد و سایر موارد هم رعایت شود سپس موادی که هر آزمایشگاه نیاز است خریداری شود در نظر داشته باشید که اگر موادی که استفاده می کنید از بهترین برند باشد مثل برند مرک کار خود را تسهیل کرده اید پس بعد از انتخاب مکان مناسب به عنوان آزمایشگاه باید موارد ایمنی را خریداری کنید مواد آزمایشگاهی شامل:( کپسول آتش نشانی ماسک و دستکش و عینک) به همراه داشته باشید تا حین انجام عملیات دچار مشکل و آسیب نشوید و موقع خرید هرنوع مواد شیمیایی باید علائم هشدار روی ظرف مواد را جدی بگیرید زیرا باید باعلائم هشداری که مخصوص مواد آزمایشگاهی است آشنا باشید تا کار با ان برایتان آسان باشد و هر علائم را باتوجه به ویژگی مواد مختص مواد قرار دهید تا اگر حین انجام کار آسیبی وارد شد با توجه به علائم هشداری که روی محصول قرار دارد برای رفع خطر متوجه باشید که چه کاری انجام دهید
خرید اینترنتی مواد آزمایشگاهی
قبل از ورود مواد آزمایشگاهی از هر مدل برندی باید برگه انالیز یا همان مجوز را دریافت کنید که هرگونه مواد تقلبی و نامرغوبی را وارد آزمایشگاه خود نکرده اید در برگه انالیز مواد اطلاعاتی درج شده است که نشان دهنده ی نوع ترکیب مواد و ریز ساختار آن را برای فرد به نمایش می گذارد سپس باید با انواع گریدی که در آزمایشگاه سرکار دارید آشنا شوید هر گرید نشان دهنده ویژگی مواد دسته بندی شده است و نشان دهنده خالص بودن و استاندارد بودن مواد را به نمایش می گذارد
خرید اینترنتی مواد شیمیایی
گرید فنی مهم ترین گرید می باشد برای اعمال غیر آزمایشگاهی نظیر شستشو و حل کردن مناسب است ما گرید های مختلفی داریم که تنها یک مورد در جهت آشنایی ذکر شد مواد آزمایشگاهی علاوه بر برگه آنالیز دارنده ی برگه ایمنی میباشند همه ی ما می دانیم که مواد آزمایشگاهی بسیار خطرناک هستند و بستگی به دما و فشار دارند یا زمان ترکیب با سایر مواد باید تمام شرایط چک شود و کنترل شود تا مشکلی پیش نیاید نام اختصاصی برگه ایمنی اطلاعات مواد آزمایشگاهی را MSDsمی نماند درست مثل یک دفترچه راهنما می ماند که قبل از کار تمام نکات و نحوه ی استفاده را به شما می گوید تا مطلع شوید اما خوب به قدری تولید کننده مواد شیمیایی بسیار می باشد که هریک اطلاعات مخصوص به خود را دراختیارتان قرار می دهد فایده ایی که دارد این می باشد که به خواننده اطلاعاتی راجب ماده نوع نگه داری کنترل ماده در اثر هرگونه احتراق هشدار می دهد در اصل نحوه ی صحیح کار با مواد را به شما می آموزد.
خرید اینترنتی مواد شیمیایی آزمایشگاهی
در دفترچه اطلاعات ایمنی چه اطلاعاتی ذکرشده جالب می باشد بدانید اطلاعاتی چون :( اطلاعات کلی محصول ،کمک اولیه، شناخت خطرات و….) در مابین 16سرتیر تنها کمک اولیه مهم می باشد و دراولویت زیرا در موقع کار با مواد آزمایشگاهی هرلحظه امکان تماس با پوست را خواهد داشت و آگاهی از این بابت در جهت کنترل آسیب بسیار مناسب می باشد و بهتر است که زمان استفاده ی درست هریک را بدانید از مواد آزمایشگاهی در جهت تجزیه ماده ای با عنصرهای مشخص استفاده می شود به همین علت می باشد که برند و اصل بودن مواد حرف اول را می زند چون با توجه به جنس و کیفیت حاصل آزمایشی که تصور کرده ایی ممکن است در هرلحظه تغییر کند مواد آزمایشگاهی با توجه به برند کاربرد خود را به نمایش می گذارد موادی که دارای برند مرک merek می باشند کاربرد بسیاری را با خود همراه دارند

در جهت تشخیص طبی استفاده می شود و باید از نظر استاندارد و کیفی بودن دائم چک شود و این برند تنها محصولات دارویی تولید می کند به همین علت در جهت تولید سرم و واکسن شناخته شده است کمپانی که مرک تشکیل داده است معتبرترین کمپانی است که در جهت تولید مواد شیمیایی آزمایشگاهی حرف اول را می زند به همین دلیل است که در صنایع آرایشی بهداشتی هم کاربرد دارد و مواد آزمایشگی موجود در آزمایشگاه در رنج اعداد 100 تا 115 است که با توجه به حروف الفبا چیده می شود و اکثرا مواد آزمایشگاهی در صنایع دارویی و غذایی استفاده می شوند برند مرک هم تولید کننده مواد دارویی است
مواد آزمایشگاهی که در مصارف عمومی قرار گرفته دارای گریدی به نام ARاست به همین علت در مصارف عمومی استفاده می شود اما به خاطر داشته باشید که گرید های بالا بیشترین کار و تخصص را در آزمایشگاه ها دارند و گرید درج شده روی محصول تا صنایع به کاربرده شده ی محصول را به شما می گوید اکثرا در صنایع ها به کار برده می شود که برند انتخاب شده نشان دهنده صنایعی می باشد که می توان استفاده کرد برند مرک که معتبر ترین کمپانی است نشان دهنده صنایع پزشکی و دارویی می باشد که در آزمایشگاه در جهت تولید داروها مورد استفاده قرار می میرد و دارای برگه ی آنالیز است و بدانید که هرمواد آزمایشگاهی به تنهایی دارای خواص فیریکی و شیمیایی می باشد که درجهت کاربرد خاصی به کار می رود و استفاده از مواد آلی بسیار مناسب است هرچندکه مقاومت کمتری هم دارد البته موادی که در آزمایشگاه به کار می رود تنها شیمیایی نیست گاهی ساختار :(یونی ،معدنی ،آلی و….) دارد که جزو ویژگی های بارز محصول به شمار می رود و باید در نظر داشته باشید که با توجه به ترکیبی که دارد آیا اسیدی یا قلیایی و بازی می باشد که با توجه با دانسته ها در موقع تولید دچار مشکل نشوید و همچنین در صنایع دارویی گاهی در آزمایشگاه بعضی دارو ها دست ساز میباشند که اهمیت بالایی دارد و امکان دارد به علت دست ساز بودن و کمیاب بودن ارزش بیشتری در برابر مواد آزمایشگاهی دیگر دارد

انواع مواد آزمایشگاهی
شرکت مرک در گرید های آزمایشگاهی خود بیشتر از 10 هزار مواد شیمیایی دارد ، تولیدی های مرک محصول هایی در زمینه ی دارویی ، آزمایشگاهی و مواد شیمیایی خاص تولید می کنند . شرکت مرک بسته به نوع کاربرد مواد شیمیایی آن ها را در گرید های گوناگونی تولید می کند . این گرید ها شامل موارد بسیاری می شود که به آن ها اشاره میکنیم : گرید تحلیلی که خلوص استثنایی آن بیشتر از 99 درصد است ، گرید آزمایشگاهی که دارای درصد خلوص بیشتر از 97 درصد می باشد و بسیار خالص می باشد ، گرید عمومی آزمایشگاهی دارای درجه های متغیر خلوص می باشد که به نوع استاندارد آن بستگی دارد ، گرید عمومی در صد خلوص آن بیشتر از 95 درصد می باشد ، گرید صنعتی کمتر از 90 درصد خلوص دارد . مواد شیمیایی مرک دارای گرید های آزمایشگاهی زیادی می باشد که عبارتند از ؛ گرید AR ، گرید CP ، گرید NF ، گرید خالص شده ، گرید استاندارد اولیه ، گرید معرف ،، گرید فنی .
به صورت کلی مواد آزمایشگاهی در رده و گروه مواد شیمیایی میباشند که ویژگی معین و ثابتی دارند مواد شیمیایی را تنها از طریق تجزیه و جداسازی عنصرها و نوع ترکیب ها در آزمایشگاه می توان شناسایی کرد و به نوع ساختار و ماده ی سازنده ی درونی مواد پی برد و مواد شیمیایی آزمایشگاهی ساختار یکسانی در صنایع غذایی و خوراکی موجود در بازار دارد و از درصد و خالصیت بالایی برخورددار هستند به طوری که از اصلی ترین مواد تشکیل دهنده در آزمایشگاه به عنوان مواد آزمایشگاهی شناخته شده و بر روی بسته بندی مواد فرمول مواد ذکر شده که نشان دهنده درصد خالصیت بالای محصول است
در موقع چیدمان باید با توجه به ویژگی شناختی که نسبت به مواد آگاه شده اید ظرف مخصوص مواد را انتخاب کنید برخی باید ظرف کاربردی تیره و مانع از نفوذ نور باشد برخی باید از شفافیت بالایی برخورد دارباشد باید تک تک این نکات را در خاطر داشته باشد و پوسترهای هشدار دهنده و تعاریفی را تولید و در مکان مناسب قرار دهید تا اگر موادی موضعی برای پوست بود و در تماس پوست قرار گرفت و اسیدی بود بتوانید با محلول بی کربنات مقدار اسید را کاهش دهید تا مانع از سوختن سطح پوست شود شیمیدانان در پی تحقیقات خود متوجه این شدند که برای هر مواد باید یک هویت شیمیایی یا جوهر شیمیایی منتخب خود را ایجاد کنند و این قضیه به قانون ثابت ترکیب مشهورشده است هویت شیمیایی یعنی چه ؟یعنی همان نام ماده عدد اتمی جایگاه ماده در جدول مندلیف و ریزساختاری که دارد شامل جوهر شیمیایی مواد می شود که باید ثابت و پایدار باشد مگر در واکنش شیمیایی که تبدیل به ماده ایی دیگر شود در این صورت جوهر شیمیایی هم متغییر می باشد و دیگر نمی توانند از هم جدا شوند و هویت شیمیایی خالص به صورت نادر یافت می شود
البته هویت شیمیایی رایج آب می باشد که ویژگی یکسانی دارد به صورتی که در آزمایشگاه ساخته شود یا از رودخانه گرفته شود فرقی ندارد و مواد شیمیایی و آزمایشگاهی از نظر ظاهر یه حالت دارد( جامد، گاز ،مایع ) که در برابر فشار و حرارت امکان دارد تغییر حالت بدهند یا با واکنشی دیگر آمیخته شود به طوری که مواد آزمایشگاهی جدیدی تولید شود اگر به دنبال مواد آزمایشگاهی با کیفیت هستید و در آزمایشگاه شما کیفیت حرف اول را می زند به شما کمپانی مرک را معرفی میکنم زیرا بهترین برند در صنایع دارویی شرکت آلمان معرفی شده است که در جهت توسعه ی بیشتر داروهای با کیفیتی تولید می کند و نظر آن ها این می باشد که چون تولید مواد آزمایشگاهی بالایی دارند کاتالوگی برایتان طراحی می کنند تا با توجه به کد مواد به آسانی خرید خود را انجام دهید شما هم می توانید در آزمایشگاه خود برای مواد آزمایشگاهی گوناگون خود کاتالوگی با شماره بندی که برای هر قفسه انجام دادید انتخاب و تهیه کنید کمپانی ها از شماره کاتالوگ در جهت نمایش دادن کلی اطلاعات مواد آزمایشگاهی برای شما استفاده می کنند تا به راحتی از (فرمول، برگه ایمنی و آنالیز ،فرمول خطی و اسامی مترادف و ….) خبر داشته باشید

فروشگاه مواد شیمیایی در تهران
شما هم میتوانید ازاین ایده بگیرید و در نظر داشته باشید چون مواد آزمایشگاهی دارای گرید است کمپانی مرک با توجه به گرید قالب یک کاتالوگ شماره ایی استفاده کرده به این منظور که اسید استریک را با 14 گرید مختلف در قالب شماره مختلف کاتالوگ تولید کرده و در کاتالوگ اصلی برند مرک 4 شماره اصلی حجم ماده را در نظر داشته است و نام برده و کمپانی مرک 6 عدد را به عنوان بیانگر خاصیت هایی چون گرید و مشخصات کالا را به راحتی به نمایش عموم مردم می گذارد و برای وزن کالا 4 عدد را هم در کاتالوگ قرار می دهند که سیاست و باهوشی کمپانی را به نمایش می گذارد و براین معنا است که بدون صرف وقت اضافی به آسانی مواد مورد نیاز خود را دریافت می کنید پس برای اینکه در بین تمام مواد آزمایشگاهی سردرگم نشوید می توانید از کاتالوگ در جهت استفاده ی درست از زمان استفاده کنید و همچنین بعضی از مواد این کمپانی که در آزمایشگاه استفاده می شود نقش حلال بودن دارند که امکان دارد رقیق یا غلیظ باشد که هرکدام ویژگی خودش را دارد و در واکنش به خوبی ظاهر می شود اما این کمپانی که نام برده شده به قدری بزرگ و نام تجاری خوبی دارد که مانند خانواده ای بزرگ حدود سی و سه هزار نفر کارمند را در میان خود در بردارد که بیش از 60 درصد تولید مواد آزمایشگاهی را برعهده دارد و این برند و برند سیگما محبوب زیادی بین دانشجویان پژوهشی دارد به همین علت تولیدات زیادی هم دارند و توصیه می شود که مواد آزمایشگاهی را از کمپانی مرک خریداری کنید زیرا هدف آن ها از تولید کیفیت و رضایت مشتری است به همین دلیل خرید مواد آزمایشگاهی هم به صورت حضوری و هم به صورت غیرحضوری امکان پذیر می باشد و با یک بار خرید موجب خرید مجدد می شودو شما مشتری دائم آنها می شوید
چون این کمپانی با نام خوبی زبان زد مردم می باشد پس اگر برند خوب را انتخاب کنید به آسانی کار شما روی غلتک می افتد و به راحتی فروش و تولید و واکنش مواد آزمایشگاهی را خواهید دید و همچنین فردی در قدیم توانسته از مواد آزمایشگاهی به نام ترکیب معدنی خاص ماده ی اوره را تولید کند و ساختار های مختلفی در بر دارند که نوع تولید را به راحتی به نمایش می گذارند اما ساختار مهم، ساختار مکعبی کریستالی می باشد که به راحتی نمایش دهنده تمام روش ساخت را به نمایش می گذارد و در نظر داشته باشید که دو نوع مواد شیمیایی آلی و معدنی تنها از نظر مقاومت باهم تفاوت دارند و مقاومت حرارتی مواد شیمیایی آلی خیلی خیلی کمتر از مواد معدنی است هرچند که به طور خالص یافت نمی شوند اما بازهم تفاوت حرارتی که دارند بسیار به چشم می آیند ما مواد آزمایشگاهی متنوع داریم که برخی اسیدی هستن و استشمام طولانی آن سبب آسیب داخلی می شود و بعضی خنثی هستند
تولیدی های شرکت مرک در زمینه های مختلفی مانند دارویی ، مواد شیمیایی خاص و آزمایشگاهی فعالیت می کنند و همچنین بیشتر از ده هزار مواد شیمیایی در گرید آزمایشگاهی خود دارند . کد هایی روی مواد شیمیایی مرک وجود دارد که خلوص ، گرید و ویژگی های محصول را بیان می کند و این کد ها 6 رقمی هستند ، کد های 10 رقمی روی مواد شیمیایی قرار دارد که شش رقم اول آن کد مواد شیمیایی است و 4 رقم بعدی وزن ماده را بیان می کند ، از مواد شیمیایی مرک در موارد زیادی استفاده می کنند که شامل مواردی چون : پالایشگاه ها و صنایع پتروشیمی ، صنایع نفت و گاز ، آزمایشگاه های تشخیص طبی ، محیط زیست ، منابع طبیعی ، تولید سرم و واکسن ، صنعت غذایی و چسب و رنگ ، وسایل بهداشتی و آرایشی ، کاشی و سرامیک ، نیروگاه برق ، آبکاری فلز ها ، آب و فاضلاب و پزشکی می باشد .
این شرکت در سال 1975 میلادی در آمریکا از مشارکت دو شرکت شیمیایی سیگما و آلدریچ تشکیل شد که در زمینه علوم زیستی فعالیت دارد حدود 10000 ( ده هزار ) کارمند دارد و در 40 کشور دنیا دارای شعبه های مختلف می باشد که بیشتر محصولات آن در زمینه دارو سازی و زیست فناوری کارایی دارد ترکیب این دو شرکت که شرکت سیگما آلدریچ می باشد مواد آزمایشگاهی بیو شیمیایی و شیمیایی آلی در جهان را ارائه می دهد این شرکت بزرگ و معروف با قدمت 40 ساله خود به دو دلیل مهم از جمله کیفیت عالی محصولات و همچنین تحویل به موقع محصولات به مشتریان، دارای طرفداران بسیاری در سراسر دنیا می باشد که روزانه بیش از یک میلیون مشتری در تمامی نقاط دنیا از محصولاتش استفاده می کنند مشتریان این شرکت شامل تعداد زیادی حدود 3 میلیون، از دانشمندان و محققان 35 کشور دنیا در زمینه علوم زیستی می باشد شرکت سیگما آلدریچ یکی از شرکت های فرعی شرکت های مرک میلی پور می باشد که در سال 2015 میلادی به طور قطعی به شرکت های مرک میلی پور پیوست و از آن زمان به بعد محصولات خود را به نام سیگما میلی پور عرضه می کند شرکت های مرک بزرگترین تولید کننده مواد شیمیایی و دارویی محسوب می شوند و موسسان و عاملین این شرکت اهداف خود را اینگونه بیان کرده اند که : " هدف ما حل پیچیده ترین مسائل علمی بشر به وسیله همکاری با جامعه علمی جهانی می باشد " یکی دیگر از اهداف بزرگ این شرکت ها سلامتی همه انسان ها با هر ملیت می باشد امروزه شرکت سیگما آلدریچ بیش از صد هزار نوع مواد شیمیایی تولید می کند که اکثر این مواد در زمینه دارویی، آزمایشگاهی، غذایی، آرایشی و مواد شیمیایی خاص می باشند که در صنایع آرایشی و بهداشتی، صنایع پتروشیمی، صنایع چسب و رنگ، صنایع داروسازی، صنایع آبکاری، صنایع کاشی و سرامیک، صنایع پتروشیمی، صنایع غذایی، نفت و گاز، آزمایشگاه های علوم زیستی ( مثل سم شناسی، میکروبیولوژی، ژنتیک، کالبد شناسی و غیره )، آزمایشگاه های کنترل کیفی و استاندارد، آزمایشگاه های تشخیص طبی و آزمایشگاه های آب و فاضلاب مورد استفاده قرار می گیرند این برند سال های زیادی است که در تمام دنیا و از جمله ایران به عنوان مشهورترین و بهترین برند تولید مواد شیمیایی مطرح است و چون در ایران دارای نمایندگی رسمی نمی باشد بنابراین نمونه های تقلبی این برند در بازار به طور فراوان موجود می باشد که این موضوع به خریداران و مصرف کنندگان مواد آزمایشگاهی زیان های بسیاری وارد می کند نمونه های تقلبی این مواد شیمیایی از هر نظر ( بسته بندی، کد مواد، شکل ظاهری ماده و تاریخ انقضاء ) کاملا شبیه مواد شیمیایی اصل می باشند بنابراین در خرید و تهیه مواد شیمیایی این برند باید دقت کامل داشت و با اطلاعات کافی اقدام کرد همچنین برای غالب نشدن مواد شیمیایی تقلبی باید از هر شخص و هر مکانی جویای مواد شیمیایی تولیدی این شرکت نباشیم بلکه باید به اشخاص و مکان های رسمی و قابل اعتماد مراجعه کرد مواد شیمیایی تولیدی این شرکت معرفی شده با استفاده از تکنولوژی های روز دنیا و با بالاترین کیفیت به بازارهای جهانی عرضه می گردد که با توجه به کیفیت بالای خود از قیمت مناسبی نیز برخوردار می باشند
کمپانی آلفا ایسر از سال 1989 میلادی فعالیت خود را در شهر ماساچوست آمریکا شروع کرده است این شرکت زیر مجموعه شرکت بزرگ و مقتدر Thermo Fisher Scientific ( ترمو فیشر ساینتیفیک ) بوده و در تولید لوازم آزمایشگاهی و مواد شیمیایی فعالیت می کند و در حال حاضر یکی از شرکت های پیشرو در امریکا است که پاسخگوی نیازهای بسیاری از متقاضیان می باشد این شرکت بزرگ با تلاش های بی وقفه خود و همچنین کیفیت بخشیدن به محصولات خود توانسته است نظر بسیاری از متقاضیان مواد شیمیایی و لوازم آزمایشگاهی از تمام نقاط دنیا را به سوی خود جلب کند و بیش از 50 سال است که تامین کننده مواد خام و اولیه برنامه های کاربردی تحقیقی و توسعه دانشمندان و محققین می باشد شرکت آلفا ایسر یک شرکت بین المللی است که محصولات خود را برای فروش به قاره های آمریکا، اروپا و آسیا می رساند و در اکثر نقاط دنیا دارای نمایندگی فروش رسمی می باشد در حال حاضر حدود 38000 محصول شیمیایی تحقیقاتی و بیش از 5000 محصول بیو شیمیایی در مقیاس های مختلف توسط این شرکت بزرگ بین المللی به بازارهای جهانی عرضه می گردد برخی از محصولات این شرکت شامل مواد معدنی، مواد ارگانیک، فلزات آلی، فلزات خالص و عناصر، ترکیبات فلزات گرانب ها و کاتالیزورها، مواد بیو شیمیایی، نانو و تجهیزات آزمایشگاهی می باشد که همگی آنها دارای کیفیت تضمین شده هستند همچنین محصولاتی نیز برای تحقیقات علمی در زمینه علوم کاربردی همچون ژنومیک، پروتئومیک، ایمونولوژی، زیست شناسی سلولی و مولکولی و تحقیقات عروقی تولید می کند شرکت آلفا ایسر می تواند سفارش های مشتریان را برای عرضه بیشتر کالاهای تخصصی دیگر بپذیرد که این قابلیت موجب شده است تا این شرکت در بین رقبای خود منحصر به فرد باشد با توجه به فراوانی محصولات این شرکت، انتخاب این برند یک انتخاب کامل برای تمامی نیازهای تحقیقاتی است محصولات این کمپانی از بهترین برندهای جهانی است که در تمام دنیا طرفداران بسیاری دارد در تولید محصولات این شرکت کیفیت حرف اول را می زند اما تنها تخصص در تولید کافی نمی باشد بلکه باید نحوه خدمات رسانی که شامل مواردی همچون دسترسی به محصول، بسته بندی و تحویل به موقع محصول می باشد نیز به طور مطلوبی انجام شود به همین علت نمایندگی های فروش رسمی این شرکت در سرتاسر دنیا از جمله ایران شبانه روز برای ارائه خدمات به مشتریان به طور مستمر در حال فعالیت هستند و به طور کل می توان گفت که این شرکت متعهد به ارائه دادن سطح بالایی از خدمات شده است که روز به روز در حال پیشرفت و رسیدن به کمال می باشد نمونه های تقلبی محصولات این شرکت در کشورمان فراوان می باشد که همواره افراد سود جویی وجود دارند که با سوءاستفاده از اعتماد متقاضیان و ارائه محصولات تقلبی به جای محصولات اصل این برند به مشتریان به دنبال سرازیر کردن سودهای کلان به سوی خود می باشند به همین دلیل برای جلوگیری و مانع شدن از سود جویی این افراد بهتر است تا اساتید، دانشجویان، محققان، دانشگاه ها، مراکز علمی و تحقیقاتی و سایر متقاضیان برای تهیه محصولات این شرکت به نمایندگی های رسمی فروش شرکت آلفا ایسر در کشورمان مراجعه نمایند تا علاوه بر اطمینان از خرید محصولات اصل این برند از خدمات پس از فروش محصول نیز برخوردار شوند
در سال 1949 میلادی در شهر بارسلونا کشور اسپانیا شرکتی به نام F.E.R.O.S.A به جهت تولید واکنشگرهای آلی تاسیس شد آقای پابلو شارلو مدیریت این شرکت در سال 1954 میلادی تصمیم گرفت که شرکت فروسا به عنوان نمایندگی رسمی یک شرکت آلمانی به نام شرکت شوشارت در اسپانیا به فعالیت خود ادامه دهد شرکت آلمانی شوشارت یک شرکت متخصص در ساخت واکنشگرهای شیمیایی به منظور استفاده در آزمایشگاه ها بود طبق توافقاتی که بین مدیران این دو شرکت صورت گرفت قرار بر این شد که از مارک آلمانی بر روی مواد واکنشگر تولیدی توسط فروسا F.R.O.S.A که در بارسلونا تولید می شد استفاده شود فعالیت های این شرکت ادامه داشت تا اینکه در سال 1970 میلادی شرکت دکتر تئودور شوشارت به شرکت دیگری واگذار شد با این پیشامد شرکت فروسا تصمیم گرفت که محصولات خود را با نام تجاری جدیدی به بازار ارائه دهد و بدینگونه شرکت فروسا به نام تجاری شارلو تغییر نام یافت در سال 1980 با فوت بنیانگذار شرکت شارلو پسرش ورنو شارلو به عنوان مدیر جدید شرکت انتخاب شد در سال 1982 میلادی اولین دسته از حلال های خود را برای HPLC تولید و به بازار عرضه نمود و با تولید این حلال ها عنوان اولین شرکت اسپانیایی تولید کننده این مدل از حلال ها را به خود اختصاص داد با نفوذ سریع این محصول به بازار و نیازهای موجود در بازار به این محصول باعث شد تا شرکت جدیدی به نام واکنشگر شارلو تاسیس شود تا علاوه بر ارائه محصولات فروسا، سایر محصولات مرتبط با کروماتوگرافیرا نیز عرضه گردد در سال 1984 واکنشگرهای شارلو اولین لیست لوازم جانبی خود را برای کروماتوگرافی HPLC اعلام کرد و بخشی در شرکت را به این منظور اختصاص داد واکنشگرهای شارلو از سال 1984 تا 1990 میلادی از لحاظ فروش و همچنین عرضه خطوط تولید به صورت چشمگیری توسعه پیدا کرد و در سال 1990 فروسا برای اولین بار موفق شد تا محصولات خود را به بازارهای مشترک اروپایی صادر کند و در سال 1991 واکنشگرهای شارلو توانست به عنوان شرکت توزیع مواد آزمایشگاهی با سه بخش واکنشگرها، کروماتوگرافی و آزمایشگاه مواد عمومی به طور مستقل عمل کند در همان سال شرکت فروسا ADSA MICRO که تولید کننده محیط های کشت دهیدراته بود را خریداری نمود که در نتیجه موجب دو کار تولید و توزیع ملی شد که این اقدام فروسا باعث ایجاد بخش چهارم کسب و کار فروسا یعنی میکروبیولوژی شد و چند ماه بعد شرکت دیگری به نام کارل راث اسپانیا تاسیس شد که زیر مجموعه شرکت شارلو قرار گرفت و وظیفه آن بازاریابی محصولات ایمنی برای آزمایشگاه ها بود در سال 1994 میلادی شرکت واکنشگرهای شارلو با شرکت ACROS ORGANIC قراداد انحصاری که شامل واکنشگرهای تحقیقاتی و مواد خام می شد را امضاء نمودند و در نهایت در سال 1999 میلادی یک سرویس مدیریت زباله آزمایشگاهی و یک وبسایت به منظور خریدهای آنلاین راه اندازی شد و بعد از مدت زمان کوتاهی نام شرکت از واکنشگرهای شارلو به شارلب تغییر یافت و از آن زمان تا به حال فعالیت های این شرکت ادامه دارد و رو به رشد می باشد و اکنون شرکت شارلب شرکتی است که همه نیازهای آزمایشگاه ها را تولید می کند و بیش از 2000 مواد آزمایشگاهی تولید می کند این شرکت در زمینه تولیدات واکنشگرهای شیمیایی، میکربشناسی، کروماتوگرافی، مواد عمومی آزمایشگاه ها، لوازم بهداشتی و ایمنی و تجهیزات آزمایشگاهی فعالیت می کند.
در سال 1991 میلادی شرکت سانتاکروز SANTA CRUZ توسط یک زوج با نام های جان استفنسون و برند استفنسون در شهر سانتاکروز کالیفرنیا تاسیس شد که دارای بیست سال سابقه کاری در زمینه آنتی بادی های مونوکلونال، بیوشیمی و محصولات CRISPR می باشد محصولات این شرکت از بالاترین سطح کیفیت برخوردار هستند هدف این شرکت ارائه کامل ترین طیف از آنتی بادی های تحقیقاتی است این شرکت در ارائه انواع آنتی بادی های تحقیقاتی از جمله آنتی بادی های اولیه و ثانویه، ویروس های بیان کننده SIRNA، آنتی بادی های اختصاصی فسفو، آنتی بادی های فعال بیولوژیکی و مواد شیمیایی عمومی دارای تخصص می باشد این شرکت با تلاش های بی وقفه خود توانست در سال 2010 میلادی محصولات خود را از چند صد عدد به بیش از 100000 محصول افزایش دهد که این افزایش محصولات این شرکت را به شرکتی بزرگ تر و موفق تر تبدیل کرد در سال 2015 میلادی محصولات مرتبط با CRISPR برای بیش از 37000 نوع موش و ژن های انسان ارائه شدند که این موضوع مورد استقبال تعداد زیادی از محققین قرار گرفت از دیگر فعالیت های این شرکت ساخت و تولید مواد بیوشیمی می باشد که با ساخت این مواد عنوان اولین تامین کننده بیوشیمی برای تحقیقات را به خود اختصاص داد که در حال حاضر بیش از 175000 محصول بیوشیمی را با برند Chem Cruz به بازار عرضه نموده است مواد شیمیایی عمومی که برای استفاده روزانه در آزمایشگاه ها توسط این شرکت تولید می گردد شامل بافرهای آماده شده، مواد شوینده و حلال ها می باشد شرکت سانتاکروز SANTA CRUZ برای تحقیقات پروتئومیکس نیز محصولاتی را برای محققین در این رابطه ارائه داده است این شرکت همچنین محصولاتی نیز در ارتباط با سلامت حیوانات از جمله لوازم دامپزشکی تولید می کند که تا چندین سال به خاطر اتهاماتی از قبیل نقض قوانین رفاه حیوانی که به آن وارد شد با وزارت کشاورزی ایالات متحده دچار مشکل بود تجهیزات آزمایشگاهی تولید شده توسط این شرکت با نام تجاری Ultra Cruz روانه بازارهای جهانی شده است تجهیزات آزمایشگاهی تولیدی این شرکت هر دو زمینه تولید و تحقیق را شامل می شود محصولاتی که با نام تجاری Ultra Cruz توسط این شرکت روانه بازار می گردند شامل مواردی همچون دستکش ها، نوارهای فیلتر و غشاها و همچنین محصولات پلاستیکی شامل صفحات چند صفحه ای، لوله سانتریفیوژ، مخروطی ها و ظروف می باشد اصلی ترین هدف این شرکت تعهد به کیفیت و خدمات بالا به مشتریان و جامعه تحقیقاتی است و تمام تلاش خود را برای خدمت رسانی بهتر به مشتریان بکار گرفته است و با تلاش های مستمر و بی وقفه خود به موفقیت های قابل توجهی در این زمینه دست یافته است
شرکت سانتاکروز SANTA CRUZ شعبه های مختلفی در آلمان، شانگهای و کانادا دارد همچنین دارای نمایندگی های رسمی فروش در اکثر نقاط دنیا از جمله ایران است یکی از نمایندگی های رسمی این شرکت در ایران شرکت سفیر آزما است که نسبت به سایر نمایندگی های موجود خدمات سریعتری ارائه می دهد و همواره می تواند محصولات این برند را در بسته بندی های مطمئن به موقع و در اسرع وقت به مشتریان تحویل دهد همچنین به صورت آنلاین نیز برای فروش محصولات این برند فعالیت دارد به طور کل می توان محصولات این شرکت را اینگونه برشمرد آنتی بادی های اولیه، آنتی بادی های ثانویه، آنتی بادی های مونوکلونال، محصولات بیوشیمی، مواد شیمیایی، پروتئومیکس و تجهیزات آزمایشگاهی. تمامی این محصولات از بالاترین کیفیت برخوردار هستند که با پیشرفته ترین دستگاه ها و با استفاده از تکنولوژی روز دنیا تولید می شوند
امروزه برای پاسخگویی به نیاز بسیاری از دانشمندان و محققین به مواد شیمیایی با کیفیت، شرکت های مختلفی ظهور پیدا کرده اند که به طور مطلوبی این مواد را تولید می کنند یکی از شرکت های تولید کننده تجهیزات و مواد شیمیایی مورد نیاز برای آنالیز کمی و کیفی آب شرکت HACH LANGE می باشد که در سال 1999 میلادی از ادغام دو شرکت HACH آمریکا و D.r Lange آلمان تشکیل شده است این شرکت دارای پیشینه 120 ساله می باشد که در این مدت توانسته است با پشتکار بدون وقفه خود به پیشرفت های فوق العاده ای دست یابد و امروزه به عنوان بهترین برند در این زمینه در سطح جهان شناخته شود همچنین به دلیل رعایت کردن موازین استاندارد و اهمیت دادن به تولید محصولات با کیفیت، دارای طرفداران بسیاری از نقاط مختلف دنیا می باشد محصولات این شرکت نامی شامل دستگاه های اندازه گیری، مواد شیمیایی و واکنش گرهای مربوطه می باشد که در زمینه های پارامترهای آب آشامیدنی، فاضلاب و تصفیه آب، آنالیز آزمایشگاهی و در محل، آنالیز فرآیندی و نمونه برداری مورد استفاده قرار می گیرند شرکت HACH LANGE در کشورهای مختلف از جمله کشورمان دارای نمایندگی رسمی می باشد که محصولات را در بسته بندی های مطمئن به مشتریان ارائه می دهد نمایندگی رسمی این شرکت در ایران شرکت کیمیا نوآور آزما می باشد که هم به عنوان فروشنده و هم وارد کننده مستقیم محصولات این شرکت نیازهای مختلف مشتریان را در زمینه محصولات شرکت HACH LANGE تامین می کند
نکته ای که باید در نظر داشت این است که همواره باید محصولات این برند را از نمایندگی های رسمی تهیه و خریداری نمود چون افراد سودجو بسیاری وجود دارند که فقط به منافع خویش فکر می کنند و با ارائه دادن محصولات تقلبی به جای محصولات اصل این برند به مشتریان ضرر وارد می کنند و موجب سرازیر شدن سود فراوان به سوی خود می شوند با تهیه محصولات این برند از نمایندگی رسمی خیلی راحت می توانیم جلوی سودجویی اینگونه افراد را بگیریم این برند امروزه بهترین و مطمئن ترین برند در زمینه تولیدات مواد شیمیایی مورد نیاز جهت آنالیز کمی و کیفی آب در سطح جهان است که در ایران نیز طرفداران بیشماری دارد
هوفمان - لا روش، یک شرکت بزرگ و معتبر سوئیسی در زمینه دارو سازی می باشد که دارای زیر مجموعه های فراوانی است و محصولات تولیدی خود را از طریق دو شرکت زیر مجموعه خود به نام های صنایع داروسازی روش و شرکت روش دیاگنوستیکس به تمام دنیا صادر می کند موسس این شرکت فریتز هوفمان می باشد که این شرکت را در سال 1896 میلادی با هدف نوآوری و جهانی شدن در شهر بازل سوئیس تاسیس نمود. لا روش نام خانوادگی همسر فریتز هوفمان بود که نام شرکت برگرفته از ترکیب این دو نام خانوادگی می باشد هسته اصلی فعالیت های این شرکت بخش دارویی آن می باشد که بیش از 30 هزار کارمند دارد نیمی از درآمد شرکت از طریق فروش محصولات دارویی حاصل می گردد دفتر مرکزی شرکت در شهر بازل سوئیس می باشد و در سراسر جهان دارای مراکز و سایت های دارویی و تشخیصی بسیاری است همچنین 5 مرکز بزرگ تحقیقاتی دارد که این مراکز در ایالت متحده آمریکا و اروپا قرار گرفته اند. کمپانی هوفمان - لا روش توسط یکی دیگر از زیر مجموعه های خود به نام شرکت روش هولدینگ در بازار بورس سیکس سوئیس دارای سهام می باشد. کمی بیش از نیمی از سهام کمپانی هوفمان - لا روش متعلق به نوادگان موسس این شرکت یعنی خانواده هوفمان با مشارکت خانواده اوئری می باشد و 30% سهام نیز به شرکت سوئیسی نوارتیس تعلق دارد. این شرکت به فعالیت های خود ادامه داد و با تلاش های نا تمام و فعالیت های مداوم خود توانست علاوه بر پیشرفت های صنعتی به پیشرفت اقتصادی نیز دست یابد درآمد این شرکت در سال 2010 میلادی به 47/49 میلیارد فرانک رسید این شرکت در کشورهای مختلف دنیا دارای نمایندگی رسمی می باشد نمایندگی رسمی آن در ایران شرکت تجهیزات آزمایشگاهی آذین است که سابقه طولانی ( بیش از دو دهه ) در واردات رسمی و توزیع مواد شیمیایی، تحقیقاتی، مواد کشت، کنترل کیفی و تجهیزات آزمایشگاهی مورد نیاز مراکز علمی، تحقیقاتی، دانشگاهی و صنعتی از روش سوئیس دارد و همواره آماده مشاوره دادن به مشتریان محصولات این شرکت می باشد شرکت تجهیزات آزمایشگاهی آذین اصل بودن و کیفیت محصولات روش سوئیس را ضمانت می کند. کمپانی هوفمان - لا روش جزء اعضای ثابت فدراسیون صنایع دارویی اروپا محسوب می گردد.
قلب یک اندام ماهیچه ای است که وظیفه خون رسانی به تمام قسمت های بدن را دارد این اندام ماهیچه ای به وسیله ضربان پی در پی خود، خون را به شریان های قلبی پمپاژ می کند و بدین ترتیب خون به تمامی نقاط بدن می رسد قلب انسان سالم به طور متوسط در هر دقیقه باید 70 بار بتپد این عضو یکی از اعضای حیاتی بدن انسان است که همواره باید به سلامت آن توجه ویژه داشت هرگونه خلل در کارکرد این عضو عواقب ناگواری را به دنبال خواهد داشت بیماری های قلبی انواع مختلفی دارند که اگر شخص از وجود آنها آگاهی یابد بهتر و سریعتر می تواند نسبت به درمان آن اقدام نماید یکی از راه های آگاهی سریع به وجود اختلال قلبی استفاده از مارکر ها می باشد هنگامی که فرد به اختلال قلبی دچار می شود بیومارکرها داخل خون پخش می شوند این بیومارکرها به وسیله مارکر های قلبی برای تشخیص بیماری در زمان کمی مورد ارزیابی قرار می گیرند برای هر نوع آسیب قلبی از جمله سندروم حاد کرونری و ایسکمی قلبی و غیره باید از مارکر مخصوص همان نوع آسیب استفاده کرد همچنین با استفاده از مارکرها می توان افرادی را که بدنشان آماده دریافت بیماری هست را شناسایی نمود مارکرها دارای انواع مختلفی هستند که می توان آنزیم کراتین فسفو کیناز با ایزو فرم عصبی _ عضلانی ( CM_MB )، آسپارتات آفیو ترانسفراز ( AST )، لاکتات دهیدروژناژ ( LDH )، تروپونین قلبی، میوگلوبین و گلیکوژن فسفریلاز ( GP ) را نام برد
مارکرهای قلبی Cardiac Markers انواع مختلفی دارند که عبارتند از : تروپونین قلبی ، میوگلوبین ، CK-MB . بیو مارکر های قلبی هنگام آسیب های قلبی در خون انتشار می یابند و همچنین با اندازه گیری نشانگر های زیستی می توانید سندروم حاد کرونری و ایسکمی قلب را تشخیص دهید . و همچنین از این تست ها می توانید در شناسایی کردن افرادی که مستعد بیماری قلبی و ریسک پذیر هستند استفاده کنید .
تست های اعتیادی / Drugs of Abuse از ویژگی ها و کاربرد های زیادی برخوردار می باشند که کاربرد های آن شامل موارد زیادی می شود که ما برای شما چند نمونه را نام می بریم ؛ برای غربالگری های پزشکی و ورزشی بسیار کارامد است ، تست های حقوقی و یا قانونی ، تست مواد مخدر استخدامی و نظارت کردن بر داروهای ضد درد . تست های اعتیادی / Drugs of Abuse برای تعیین کردن داروهایی که در ادرار و خون افراد وجود دارند مورد استفاده قرار می گیرند ، لازم به ذکر است که بدانید تست های مختلفی برای هرکدام از دارو های اعتیادی وجود دارد مثلا ، برای سنجیدن آمفتادین ، متادون ، حشیش و مورفین تست های مجزایی در نظر گرفته شده است.
تست های اعتیادی / Drugs of Abuse به صورت پنل هستند که به طور همزمان دارو های اعتیادی را به صورت چندتایی تشخیص می دهند . هنگامی که در یک نمونه ی ادرار آمفتامین و یا داروی دیگری وجود داشته باشد ، مهاجرت مویرگی به سمت بالا می رود و یک پیوند با آنتی بادی موجود بر قرار می کند ، در نوار یک خط رنگی دیده می شود که نشانگر مثبت بودن نتیجه ی آزمایش می باشد . مهم ترین تست های اعتیاد عبارتند از ، اکستازی ، مرفین ، مت آمفتامین ، آمفتامین ، بنزودیازپین ، تری سیکلیک استیک اسید و یوپرونورفین می باشند . محصولات تست های اعتیادی / Drugs of Abuse شامل موارد زیادی می شود که چند مورد را برای شما نام می بریم ؛ پنل 10 تستی اعتیادی ، پنل 5 تستی اعتیادی ، پنل 3 تستی اعتیادی ، کیت حشیش ، کیت ترامادول ، کیت کوکائین و کیت متادون از محصولات آن می باشند .
غده هایی که ترشحات را به طور مستقیم به جریان خون می ریزند و از طریق خون به نقاط مختلف بدن می روند و روی سلول ها تاثیر می گذارند غده های درون ریز هستند . نقش این غدد درون ریز عبارتند از " وضعیت روانی را تنظیم می کند و همچنین در عملکرد بافت ، فرآیند های تناسلی بدن ، رشد و متابولیسم کاربرد دارند .
غدد های اصلی که در سیستم غدد درون ریز انسان هستند شامل : غده ی آدرنال که آزاد سازی هورمون کورتیزول را بر عهده دارد ، غده ی هیپوتالاموس که از هیپوفیز برای آزاد سازی هورمون ها پیام ارسال می کند ، تخمدان که وظیفه ی آن تولید کردن هورمون های جنسی زنانه است ، بیضه که هورمون جنسی مردانه و اسپرم تولید میکند ، پاراتیروئید نقش مهمی در رشد و نمو استخوان ها دارد ، پانکراس آزاد سازی هورمون های گلوکاگن و انسولین را کنترل میکند ، غدد صنوبری در نزدیک قسمت مرکزی مغز قرار گرفته است که امکان ارتباط با الگوهای خواب را دارد ، تیرویید در کنترل کردن متابولیسم کارایی دارد ، تیموس در آغاز زندگی به سیستم ایمنی بدن کمک میکند و غده ی هیپوفیز که روی هورمون ها به خصوص هورمون تیروئید تاثیر می گذارد . تست های غدد درون ری?












